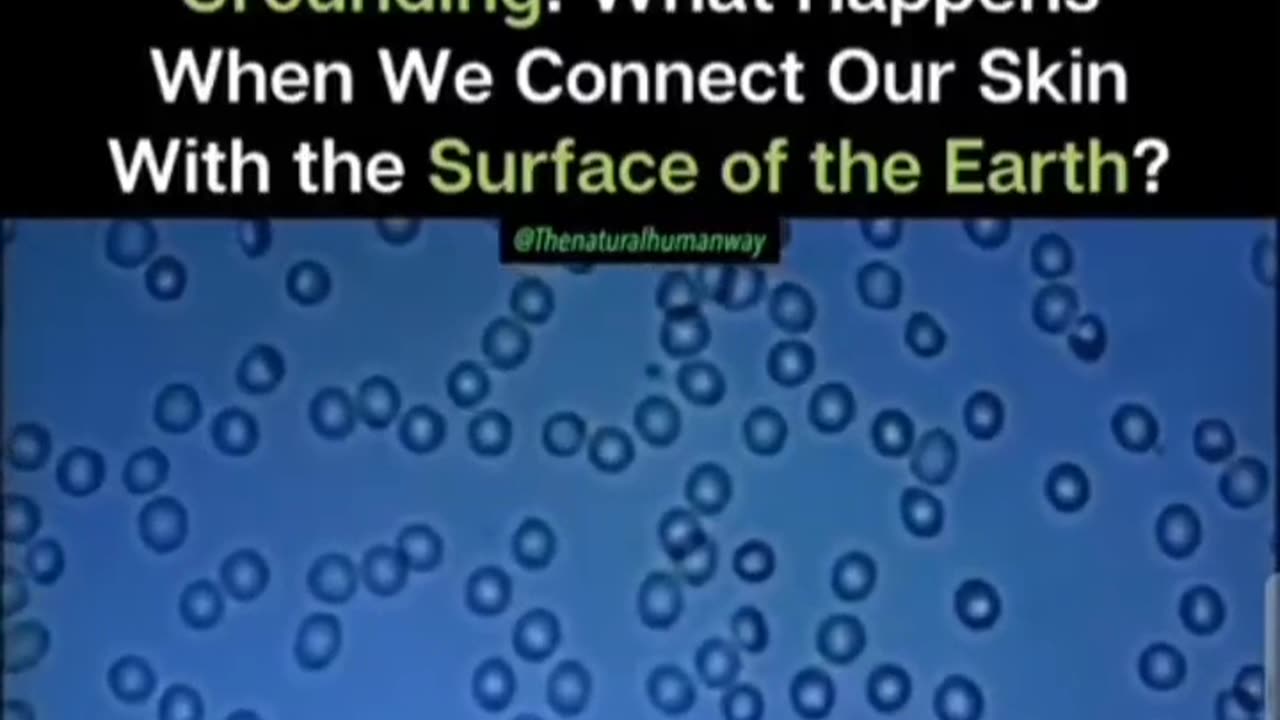
The transfer of free electrons from the Earth to the body is essentially instantaneous.

Premium Only Content
The transfer of free electrons from the Earth to the body is essentially instantaneous.
The actual physiological benefits, such as reduced inflammation, normalized cortisol levels, and improved blood viscosity, develop quickly with consistent grounding.
https://t.me/BeforeOurTime/13267
📍📍📍📍📍📍📍📍📍📍📍📍📍
Always Question the algorithms ™ 🤔 AlgorythemQ
I am the producer of some of this content.
I provide all of it for your entertainment only...
The telegram links in the description are just that, links to the video.
"Conspiracy Theorist" Think everything is a cover-up!
We question EVERYTHING, do OUR research and come to conclusions that scare YOU!!!
BTW I still haven't monetized all four of my channels and most videos are from social media.
"In politics, nothing happens by accident. If it happens, you can bet it was planned that way."
Franklin D. Roosevelt
No information is intended to nor implied to be medical advice.
"The World Thru Qz Eyes". https://www.algorythemq.com/
My X account: https://twitter.com/AlgorythemQ
-
 1:59
1:59
North South Specialties Productions
1 day agoSpars pandemic 2025 - 2028? Don't fall for the lies of germs jumping all over.
37 -
 4:24
4:24
Gamazda
17 hours ago $0.57 earnedDeep Purple – Smoke On the Water (Live Piano Cover in a Church)
3.42K9 -
 12:54
12:54
Brad Owen Poker
12 hours agoI Make Final Table! I’m Going To $10,400 WPT World Championship!!
3.67K2 -
 10:00
10:00
TheMightyMcClures
22 days agoWe Fed 500 Families!
37 -
 6:23
6:23
The Shannon Joy Show
12 hours agoWas Covid a MILITARY OPERATION?
5031 -
 LIVE
LIVE
The Bubba Army
21 hours agoTRUMP SIGNS EPSTEIN BILL! - Bubba the Love Sponge® Show | 11/20/25
2,857 watching -
 27:24
27:24
DeVory Darkins
20 hours agoTrump secures RECORD BREAKING INVESTMENT as Charlotte Schools issue SHOCKING Update
22.2K41 -
 34:15
34:15
ZeeeMedia
15 hours agoPolice Demand Government Critic Hands Over His BLOOD | Daily Pulse Ep 147
47.3K33 -
 1:47:50
1:47:50
Side Scrollers Podcast
15 hours agoSide Scrollers Presents: OVERCOCKED
31.6K12 -
 3:33:22
3:33:22
HLL8LLY
4 hours agoBattlefield 6 Live Gameplay
508